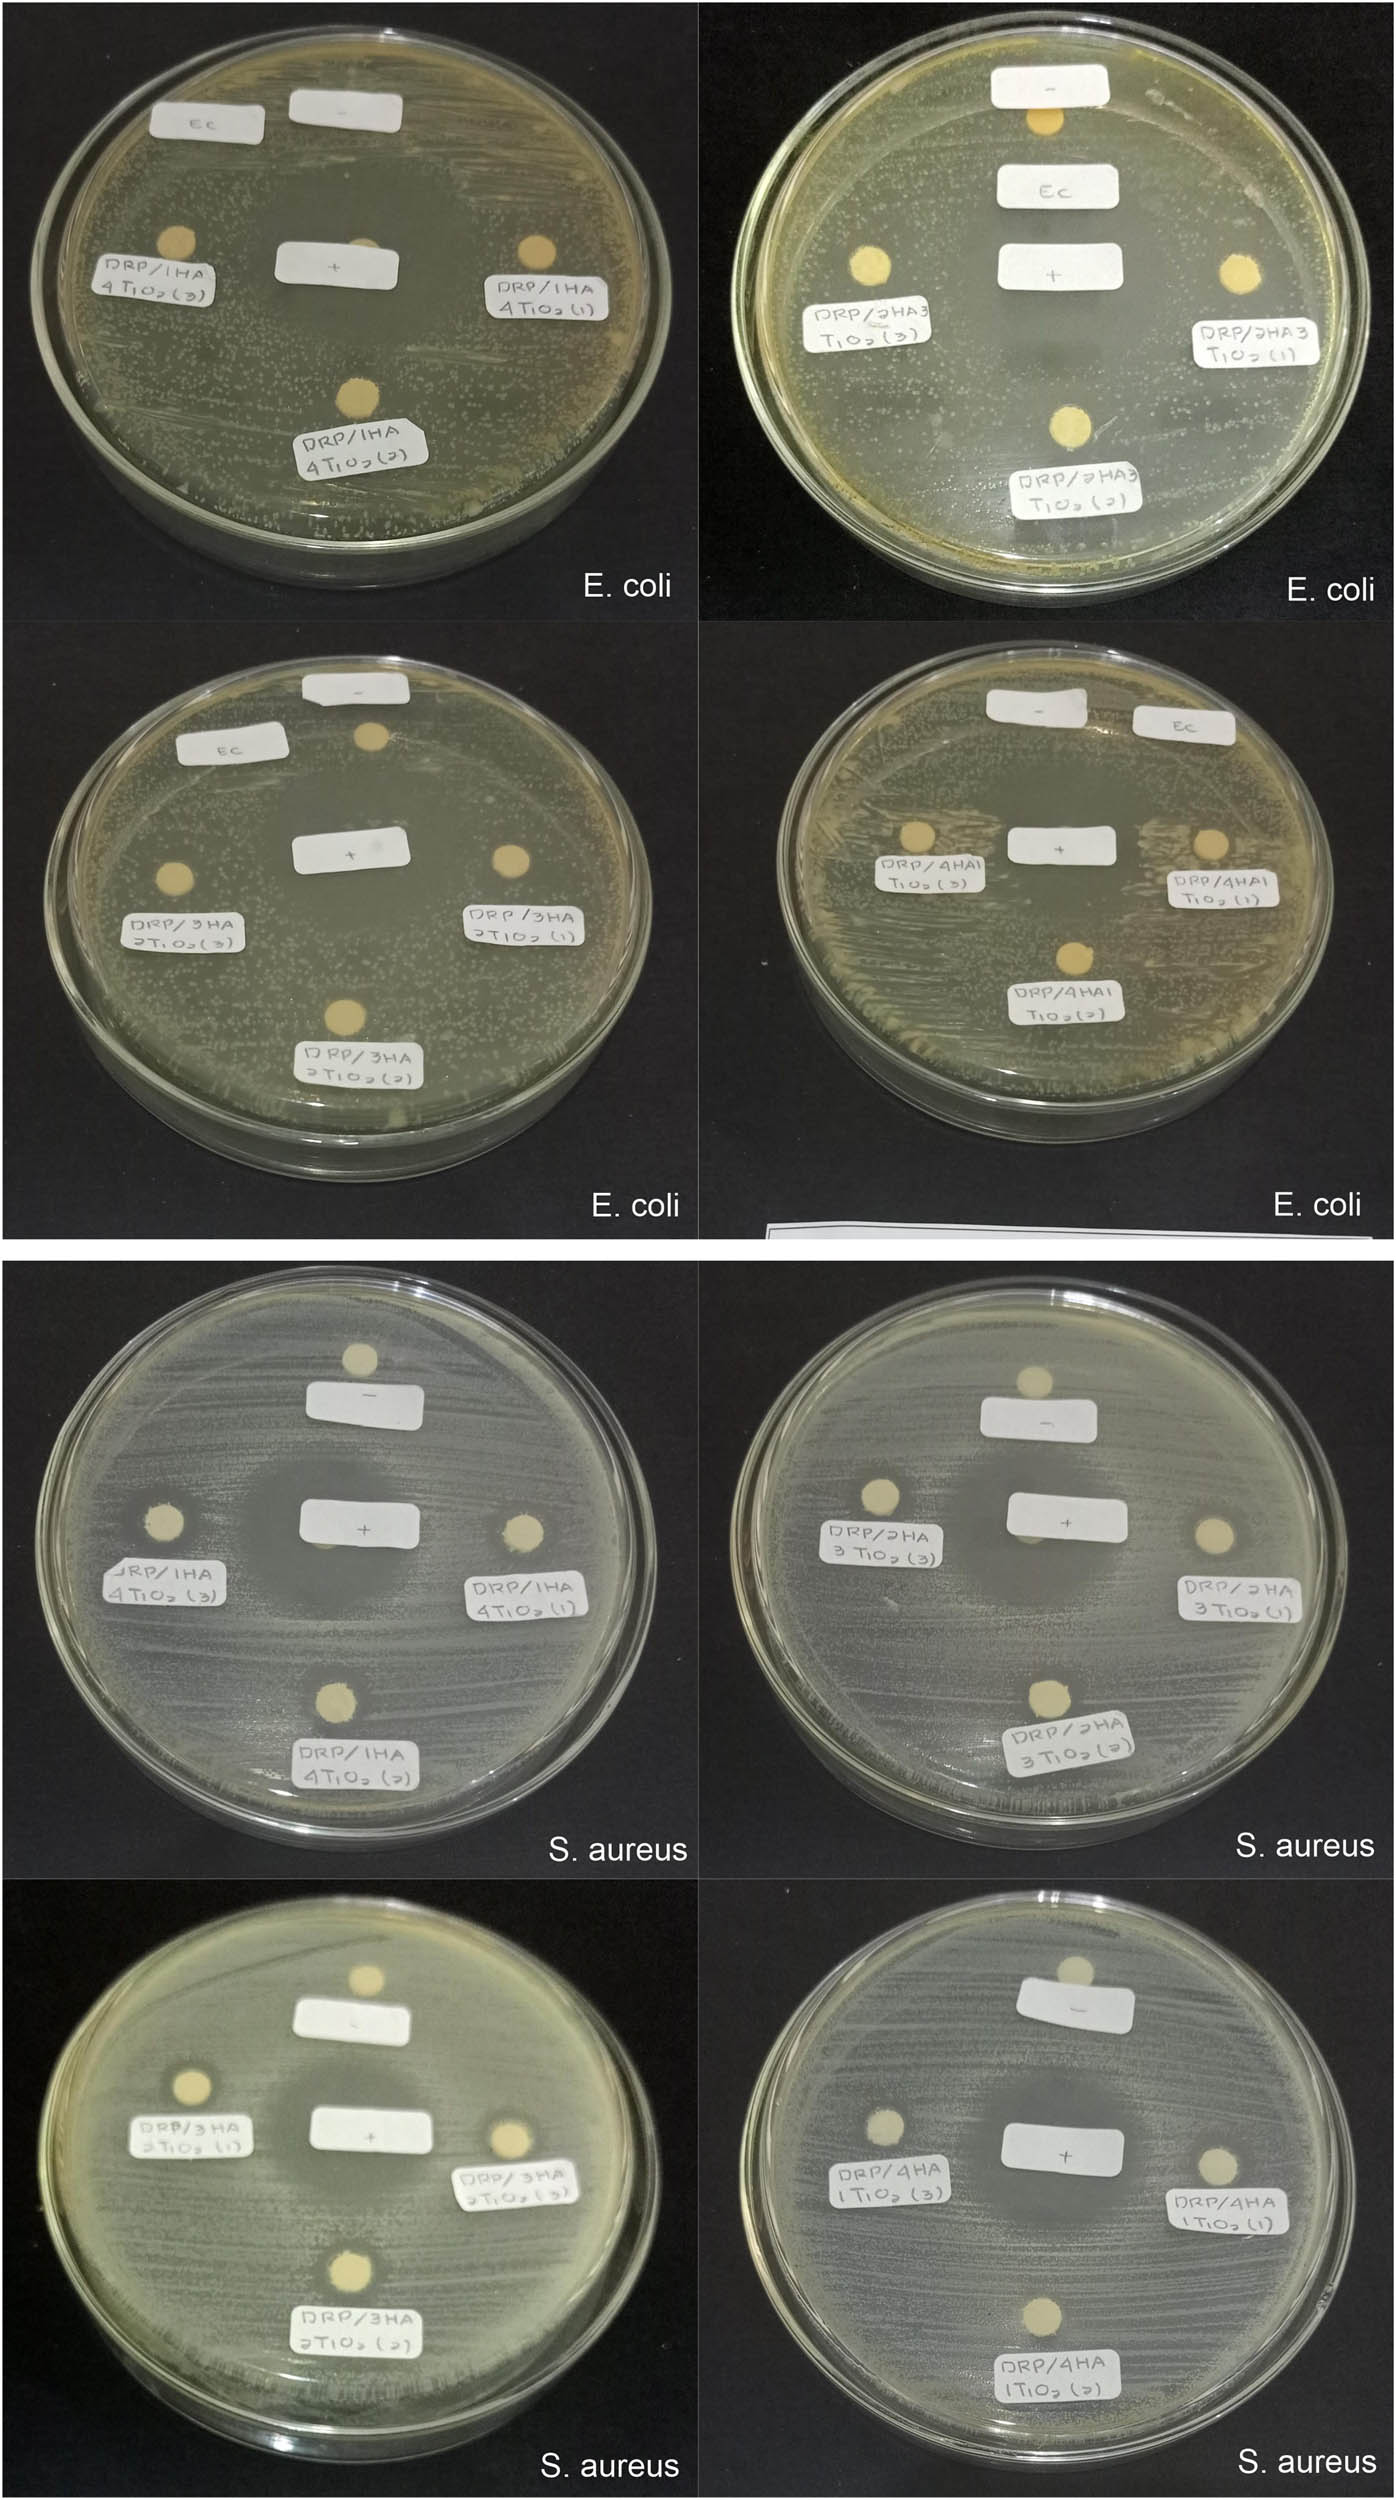
Figure 8
Zone of inhibition of 3D-printing specimens against E. coli and S. aureus bacteria: Control positive (+); control negative (−); DRP with the additive HA–TiO2 at various concentrations.

Mechanical and antibacterial characteristics of a 3D-printed nano-titanium dioxide–hydroxyapatite dental resin-based composite
-
Rohmadi
, Ubaidillah, Kuncoro Diharjo
, Joko Triyono , Widyanita Harwijayanti , Sunarto Kaleg and Saiful Amri Mazlan
Abstract
Titanium dioxide (TiO2) and hydroxyapatite (HA) nanoparticles are used to improve the mechanical performance and biological integration of dental implants. One of the manufacturing methods widely used for making implants is 3D printing. In this research, a TiO2 and HA nanoparticle composite is used as the additive to the dental resin photopolymer matrix for the stereolithography method. Herein, nanoparticles at 1, 2, 3, and 4 wt% concentrations were mixed with the resin to produce composite specimens. Hardness, tensile, impact, and wear tests were conducted to evaluate the mechanical properties of the composite material. The particle distribution and surface morphology were revealed by scanning electron microscopy. The mechanical properties of material showed fluctuating results due to particle agglomeration, micro-voids, and poor interfacial bonding of the matrix and nanoparticles during mixing and printing. Antibacterial activity of the composite material was examined by the Kirby–Bauer method using Escherichia coli and Staphylococcus aureus bacteria. The highest inhibition zone occurred around the sample with the composition 2 wt% HA and 3 wt% TiO2 against both bacteria. For S. aureus, the inhibition zone occurred in almost all sample compositions compared to E. coli due to plasmolysis in the bacterial cell wall.
1 Introduction
The field of dental restorations and implants has undergone a transformation as a result of the development of biomaterials and the rise of additive manufacturing technologies such as 3D printing. In order to prevent issues such as infections, researchers are concentrating their efforts on the development of new composite materials that not only have the ability to provide increased mechanical strength but also exhibit antibacterial qualities. Nano-titanium–hydroxyapatite (Ti–HA)-reinforced dental resins have garnered a significant amount of attention among these materials. Titanium, which is known for its biocompatibility, strength-to-weight ratio, and corrosion resistance, is an ideal choice for biomedical applications. On the other hand, hydroxyapatite (HA), which is the major mineral component of bones, is highly bioactive, in that it promotes osseointegration and bioactivity [1,2]. However, there is still a challenge in optimising these materials for dental applications, which require a mix of mechanical performance and biological integration, a fundamental aspect of dental applications.
New opportunities for enhancing the performance of conventional dental composites have become available because of the incorporation of nanotechnology into the process of dentistry. Nano-sized particles have a high surface area-to-volume ratio, which results in improved reinforcement when they are incorporated into polymer matrices. In particular, nano-titanium enhances the mechanical qualities of dental resins, such as tensile strength, hardness, and wear resistance. This makes the materials more durable, which is beneficial for usage in dental prostheses that are subjected to severe stresses [3,4]. The nanoscale form of HA improves biological compatibility by closely imitating the mineral structure of real teeth and bones, which in turn promotes greater integration with the tissues that are around it [5].
Because of its bioactivity, HA is frequently employed in dental applications. In particular, it is capable of promoting osteoconductivity and cell proliferation [6], both of which are essential for the success of implants [7]. Nevertheless, the intrinsic brittleness and low fracture toughness of HA are factors that restrict its mechanical performance, particularly in applications that include load-bearing [8]. It has been demonstrated through research that doping HA with metal ions such as titanium can enhance its mechanical properties and even introduce antibacterial effects, thereby transforming it into a versatile material that can be used for composite dental applications [1].
The prevention of bacterial adhesion and biofilm formation continues to be one of the most critical issues in dental restorations. This is especially true in the area surrounding implants, where infections can lead to serious consequences such as peri-implantitis. The oral cavity is home to a wide variety of bacteria, including Streptococcus mutans, which have the potential to colonise dental implants. Titanium nanoparticles have been found to possess antibacterial characteristics by releasing metal ions that rupture the membranes of bacterial cells, hence lowering the survival of the bacterium [9]. Furthermore, due to the surface properties of HA, it also helps decrease the adhesion of bacteria [10]. As a result of this dual action, nano-Ti–HA composites are an intriguing possibility for the prevention of infections in dental applications [11].
The introduction of technology that enables 3D printing has further revolutionised the industry by making it possible to precisely customise dental restorations. Unlike traditional manufacturing processes like moulding and casting, which can have difficulty in creating complex geometries, 3D printing provides the potential to produce elaborate, patient-specific prostheses with a high degree of accuracy [12]. Moulding and casting are two examples of traditional manufacturing techniques. When paired with the capability of directly embedding nanoparticles in the resin matrix during the printing process, this customisation offers up new options for improving the mechanical properties of dental composites as well as their antibacterial properties [13]. The incorporation of nanoparticles such as titanium and HA into nano-enhanced stereolithography (SLA) resins has been the subject of recent research [14]. These nanoparticles have been shown to be capable of achieving outstanding mechanical qualities such as hardness and tensile strength.
Fewer studies have investigated the antibacterial properties of nano-reinforced dental composites or the synergy between mechanical strength and long-term antibacterial efficacy. Although various studies have concentrated on the mechanical qualities of these composites, the antibacterial properties have not been investigated. For example, Alshamrani et al. [7] evaluated the mechanical and biocompatibility features of 3D-printed dental resins supplemented with glass silica and zirconia nanoparticles. They found that the resins exhibited considerable improvements in both the hardness and biocompatibility of the material. On the other hand, not much research has been conducted to thoroughly evaluate the mechanical and bactericidal properties of Ti–HA composites in the context of 3D printing [3,15].
There are a number of research studies available that provide evidence that nano-Ti–HA composites possess antibacterial properties; however, there is still a lack of understanding on how these qualities might be optimised specifically for dental applications that are manufactured via 3D printing. Titanium-doped HA coatings on implants have been shown to inhibit bacterial adhesion and biofilm development, which is an essential factor in the prevention of peri-implantitis, according to Liu et al. [8]. On the other hand, the primary focus of this investigation was on coatings rather than bulk composites. In a similar manner, researchers such as Berger et al. [11] and Kawashita et al. [12] investigated the antibacterial effects of silver-doped materials. However, silver can be a cytotoxic substance, which is why titanium and HA are more appealing options for dental applications [8].
The majority of these research studies fail to integrate the mechanical and biological performances in the context of 3D printing, despite the fact that they exhibit potential antibacterial effects. There was therefore a dearth of thorough studies that integrate the mechanical properties and antibacterial performance of nano-Ti–HA dental composites that are particularly created utilising 3D printing technology. This is the research gap that exists. Additionally, in order to design dental materials that are successful over the long term, it is essential to strike the appropriate balance between various properties of strength, wear resistance, and antibacterial efficacy [16,17].
A 3D-printed nano-titanium dioxide–HA dental resin-based composite is the subject of this study, which intends to fill this gap by evaluating the mechanical and antibacterial properties of the composite. This study aims to contribute to the development of innovative dental materials that improve clinical results by analysing critical factors such as tensile strength, hardness, wear resistance, and antibacterial activity. Specifically, the study will evaluate these parameters. By addressing both mechanical demands and infection risks, the combination of nanotechnology and 3D printing technology has the potential to considerably improve the performance of dental restorations [18]. This would result in an extension of the lifespan of dental implants. Although, earlier study has shown that nano-titanium and HA have the ability to enhance the mechanical and antibacterial properties of dental composites, there is an undeniable demand for research that incorporates these materials into 3D printing. In this research, a dental resin photopolymer (DRP) was combined with titanium dioxide and HA nanoparticles to overcome the constraints that are currently associated with dental materials. It could result in the development of a new generation of dental implants that are not only more durable but also more resistant to bacterial colonisation, which would eventually lead to better outcomes for patients.
2 Method
2.1 Material preparation
This work used Creality Sky Series, China, SLA type 3D Printer, for fabriaction all samples. The photopolymeric resin used during experiment was e-Sun Dental Resin, Esun Industrial, China. Titanium dioxide (TiO2) and HA nanoparticles were used as the additive. First, TiO2 nanoparticles and HA as the additive were mixed with the DRP using an ultrasonic mixer for 90 min to increase the distribution of nanoparticles with resin, breaking up the lumps, and achieve homogeneity in the mixture of DRP and nanoparticles. Before printing, the geometry of the specimen was designed with computer-aided design. The specimen was subject to a slicing process using Halot Box (Creality Cloud) software with the design that had been saved in STL (stereolithography) format. The specimen preparation procedure is shown in Figure 1. A motor speed of 5 mm/s, a layer height of 0.05 mm every stage, a bottom layer of 2, and 8 mm retraction in every stage were used as parameters of the 3D-printing process. These parameters were used considering the ability of the 3D printing machine to produce specimens with fine hardness surfaces.

3D-printing specimen preparation with SLA.
The DRPs with various compositions of TiO2 and HA nanoparticles are shown in Table 1. These compositions were chosen to improve clinical testing and define the optimum nanoparticle composition.
Various DRPs and additive (TiO2 and HA) compositions
| Materials | Composition (wt%) | |
|---|---|---|
| TiO2 | HA | |
| DRP | — | — |
| DRP/1HA4TiO2 | 4 | 1 |
| DRP/2HA3TiO2 | 3 | 2 |
| DRP/3HA2TiO2 | 2 | 3 |
| DRP/4HA1TiO2 | 1 | 4 |
2.2 Material characterisation
Several tests were conducted to determine the mechanical, morphology, and tribological properties of SLA 3D-printing materials with the additive TiO2 and HA nanoparticles. Tests included the hardness test, tensile test, wear test, impact test, and scanning electron microscopy (SEM). Hardness testing was carried out according to ASTM D785-03 [19] using a Rockwell-R Hardness Tester (Zwick/Roell, Germany) with a major load of 60 kg, a minor load of 10 kg, and an indenter diameter of 12.7 mm. The test had been done at room temperature, with a specimen thickness of 6 mm. The result of the Rockwell-R method was obtained from the depth of indentation at minor load to major load and back again to the minor load.
The tensile test was carried out according to ASTM D638-14 [20] using a Universal Testing Machine (UTM). A dog-bone shaped specimen with an overall length of 165 mm, a width of 19 mm, and a thickness of 2.8 mm was examined for tensile testing with a loadcell of 2 kN and a speed of 1 mm/min until fracture. The tensile test was performed with five replications for each material, as shown in Table 1. Strain measured by the change in the length after testing was divided by the initial length of specimen before testing, and stress was calculated by dividing the force with the cross-sectional area [21], while strain was measured with a displacement sensor that had already been installed in the UTM to log the displacement, and stress–strain curves were recorded as the results of tensile test.
Specimen with a length of 63.5 mm, a width of 12.7 mm, and a thickness of 3.17 mm was subjected to the izod impact test according to ASTM D4812-99 [22]. The impact test was carried out with five replications for each material. Impact strength (J/m2) can be estimated by dividing the impact energy (J) by the cross-section area of material (m2) as follows:
where
In accordance with ASTM G99 [23], the wear test was conducted using a tribometer machine at Laboratorium Material, Universitas Sebelas Maret, Indonesia. This method used pin-on-disk to determine the wear rate of material during friction. The sliding speed of 2 m/s, nominal load of 2 kg, track length of 1,800 mm, and wear force of 22.24 N were used as parameters for this test. Wear rate can be obtained from this material testing. Morphological examination of surface specimens was carried out by the SEM method. For SEM observations, we used a JEOL JSM-IT200 (JEOL Group, Japan) up to 3,000× magnification. 3D-printing specimens with various compositions of TiO2 and HA nanoparticles as the additive in the resin matrix were examined.
2.3 Antibacterial activity
The Kirby–Bauer method in accordance with ISO 10993-5 [24] was used to examine the antibacterial activity of specimens containing the DRP with the additive TiO2–HA nanoparticles in Laboratorium Terpadu, Universitas Sebelas Maret, Indonesia. Gram-negative Escherichia coli (ATC25922) and Gram-positive Staphylococcus aureus (ATC25922) bacteria were used for the study. The specimens were dissolved in dimethyl sulfoxide (DMSO) to form an extract, which was used for the sample test. Antibacterial activity using an indirect contact with the medium. First, a suspension of cells was stirred continuously in each glass beaker and spread on the surface in a horizontal rotation direction. The cell suspension was incubated at 37°C until the cells grew fully in a glass beaker. The culture medium was mixed with melted agar to obtain a final concentration between 0.5 and 2% and then poured into a Petri dish. The sample test in extract form was placed on each hardened agar in a Petri dish. Every Petri dish contained DMSO as a negative control and chloramphenicol disc as a positive control. The diameter of the disc was 6 mm. The Petri dish was incubated at 37°C for 24 h. After that, the inhibition zone which formed around the disc was measured using a Vernier calliper. The test was carried out using the triplo method (n = 3) for every sample compositions.
3 Results and discussion
3.1 Hardness test
DRP specimens with the additive of titanium dioxide and HA nanoparticles were subjected to mechanical testing. Figure 2 shows the Rockwell-R hardness test of the 3D-printing specimen. DRP as a control has a hardness of 93.1 HRR. The highest hardness of 113.97 HRR was obtained for DRP with 4 wt% TiO2 additive, which was increased by 22.4% compared to pure DRP. The significant increase in hardness occurred due to expansion of the surface area after the addition of nanoparticles so that the contact area between the matrix and particles also increased [25]. In the composition 3 wt% TiO2, the hardness increased by 1.8% to 94.77 HRR, and in composition 2 wt% TiO2, it decreased by 2.2% to 91.07 HRR. In the specimen with a composition of 4% wt HA, it increased by 6.1% to 98.8 HRR compared to pure DRP. The results show that the hardness values fluctuate based on the ratio of HA and TiO2, with the highest hardness observed for the DRP/1HA4TiO2 sample. The change in the hardness material is caused by adhesion between nanoparticles and the photopolymer resin and also the appearance of agglomeration after the addition of nanoparticles to the matrix [26]. A clear correlation can be drawn between the hardness and the mechanical performance observed in the impact energy tests, where the balance of HA and TiO2 plays a crucial role in defining the overall mechanical properties of the composite.

Rockwell-R hardness test of the 3D-printing specimen using DRP with the HA–TiO2 additive.
The reduction in hardness observed in DRP/2HA3TiO2 and DRP/3HA2TiO2 can be attributed to the higher composition of HA, which introduces brittleness and reduces the composite ability to resist deformation. Basak et al. demonstrated that while HA contributes to bioactivity, it often compromises mechanical strength and hardness due to its brittleness when not adequately supported by tougher materials like TiO2 [27]. This brittleness is evident in the lower hardness values of the DRP/3HA2TiO2 sample, where the increase in HA content (3 wt%) led to a decline in hardness.
Interestingly, the slight recovery in hardness in the DRP/4HA1TiO2 sample suggests that a reduction in the HA content allows TiO2 to exert a stronger toughening effect, which reinforces the matrix and prevents further reduction in hardness. The balance between HA and TiO2 contents is crucial for optimising the mechanical properties of the composite, as observed by Ramesh et al., who noted that the ratio of HA combining with another material must be carefully tuned to achieve desirable properties and benefit from each of the components [28]. TiO2 is a ceramic material known for its high hardness, and its addition to a resin matrix enhances hardness by restricting the movement of polymer chains, thus increasing resistance to indentation. The nanoparticles act as crack inhibitors, delaying the propagation of microcracks by strengthening and stacking particles bonding, which contributes to higher hardness values [29]. On the other hand, HA is brittle and tends to introduce microstructural defects, such as voids or weak interfaces, which reduce the hardness of the composite. At lower concentrations, the reinforcing effects of HA are not as detrimental, allowing TiO2 to dominate the mechanical behaviour of the composite and maintain higher hardness [27,30].
3.2 Tensile test
The dog-bone shaped material was used for the tensile test of 3D-printing specimen with the additive TiO2–HA nanoparticles. Tensile force was applied to the specimen to find out stress and deformation in determining material performances based on the strength and elasticity [31]. The ultimate maximum tensile strength in specimen 3D-printing is shown in Figure 3. The value can be achieved using Eq. (2) as follows:
where

Ultimate tensile strength of the 3D-printing specimen using DRP with the additive HA–TiO2.
From the results, the maximum tensile strength of the pure DRP 3D-printing specimen was calculated as 45.72 MPa. This corresponded to the range of resin model dental specification as matrix resin photopolymer in producing 3D-printing SLA materials [32]. The highest ultimate tensile strength was obtained for the composition 4 wt% TiO2 with 96.36 MPa. The tensile strength decreased to 42.46 MPa in 3D-printing specimen with 1 wt% TiO2 composition. Meanwhile, in compositions 2 and 3 wt% TiO2, the ultimate tensile strength was 52.52 and 51.15 MPa, respectively. The presence of additive nanoparticles certainly had an effect on the mechanical properties of materials [31]. In the tensile test, the initial specimen applied with a tensile force experienced an increase of the length until deformation occurred, which began with necking until complete material fracture [33]. Stress is defined as force divided by cross-sectional area of materials in N/mm2 units. Strain is defined as the change in the specimen length divided by its initial length [21]. Stress–strain curves of 3D-printing specimen DRP with additive TiO2–HA nanoparticles are shown in Figure 4(a).

(a) Stress–strain graph of the 3D-printing specimen using DRP with the HA–TiO2 additive; (b) specimen after the tensile test.
Pure DRP possessed a maximum tensile strength of 45.72 MPa and a maximum strain of 0.25 mm/mm at the maximum tensile strength. Meanwhile, the stress–strain curve of composition 4 wt% TiO2 nanoparticles showed high tensile strength but was not elastic enough. The maximum tensile strength was 96.36 MPa and the maximum strain was 0.12 mm/mm. In this condition, no stress was transferred, and it indicated early fracture [26]. Fluctuation occurred in another composition after the tensile test, which may be caused by swelling, agglomeration, and interfacial bonding in the polymer matrix due to the additive nanoparticles. Swelling led to increasing internal pressure from nanoparticles until the polymer chain bonds are broken and induce the change of material mechanical properties [34].
In Figure 4(a), the stress–strain graphs of various research studies showed elastic material deformation until the fracture point was reached. This condition caused the specimen not able to return to its original shape after a static load was applied [35]. It can be observed through the fracture of the specimen after test in Figure 4(b). Specimen fracture happened after reaching the ultimate tensile strength and showed an increase in the length during testing.
3.3 Wear test
The wear test was done by a pin-on-disc method to determine the wear rate of materials, which is defined as the volume loss divided by load multiplied with the length of disc due to friction between the specimen surface and the instrument surface. Wear rate refers to material degradation caused by the relative movement between two surfaces in contact [36]. Pure DRP and various composition TiO2–HA nanoparticles were used for material testing. The wear rate of the 3D-printing specimens is displayed in Figure 5.

Wear rate of 3D-printing specimens using DRP with the HA-TiO2 additive.
The wear rate for pure DRP was 1.28 × 10−7 mm3/Nm, indicating its relatively low wear resistance under repeated sliding conditions. It is expected, as the unreinforced photopolymer lacks the microstructural rigidity required to withstand mechanical abrasion, leading to plastic deformation and material deterioration. Meanwhile, the addition of HA to composition of 1% wt was 5.96 × 10−8 mm3/Nm. From Figure 2, it can be observed that the 3D-printing specimen with composition DRP/1HA4TiO2 showed the highest hardness value of 113.97 HRR and the lowest wear rate of 5.96 × 10−8 mm3/Nm. This mixture exhibited the maximum hardness, reinforcing the established association between hardness and wear resistance in polymer nanocomposites. The elevated concentration of TiO2 was probably the primary factor contributing to the improved wear performance. TiO2 nanoparticles have significant intrinsic hardness, which can enhance surface integrity and resistance to abrasive pressures. The lower the wear rate of material, the higher its hardness, so the wear rate is inversely related to material hardness [37]. Furthermore, the small particle size and large surface area facilitate improved interaction with the polymer matrix, leading to better load distribution and the reduction of micro-crack formation during frictional contact.
In DRP/2HA3TiO2, DRP/3HA2TiO2, and DRP/4HA1TiO2, the wear rate escalated progressively to 7.86 × 10−8 mm3/Nm, 9.56 × 10−8 mm3/Nm, and 1.12 × 10−7 mm3/Nm, respectively. This trend indicates that although HA enhances bioactivity and interfacial interaction within the polymer matrix, its contribution to wear resistance is inferior to that of TiO2. HA has comparatively reduced hardness and may be more prone to detachment or fragmentation under sliding circumstances, especially at elevated concentrations. Furthermore, excessive loading of HA heightens the likelihood of particle agglomeration, which may create stress concentrators and diminish the overall mechanical integrity of the composite [26].
The observed wear behaviour corresponds to the theory that wear resistance is inversely proportional to the extent of plastic deformation and surface damage. In DRP/1HA4TiO2, the synergistic influence of a minimal quantity of HA, likely augmenting polymer–filler adhesion coupled with the predominant presence of TiO2, yields a nanostructured composite characterised by enhanced interfacial strength, load-bearing capacity, and micro-abrasion resistance. As the TiO2 content diminishes, the mechanical reinforcing effect is diminished, resulting in an elevated wear rate despite the concentration of HA.
The result aligned with the research conducted by Yahyaa and Aleabi [29], who demonstrated that TiO2 nanoparticles significantly enhance the mechanical properties. Moreover, the marginal increase in wear rate at elevated total filler concentrations may be ascribed to the diminished dispersion efficiency and inadequate wetting of filler surfaces by the resin, which are prevalent issues in nanocomposite processing.
The wear resistance of 3D-printed dental resin composites can be markedly enhanced by integrating HA–TiO2 hybrid nanoparticles, with the optimal composition determined as DRP/1HA4TiO2. This formulation exhibits optimal equilibrium between mechanical reinforcement and interfacial adhesion, indicating that TiO2 predominantly contributes to wear resistance, but a small quantity of HA offers supportive effects without undermining dispersion and matrix integrity. These findings underscore the significance of optimising the filler type, proportion, and distribution in the formulation of high-performance dental restorative materials.
3.4 Impact test
The impact test results for the SLA 3D-printed DRP composites with varying contents of HA and titanium dioxide (TiO2) are shown in Figure 6. The results demonstrate that nanoparticle addition affects the material’s mechanical properties, particularly the impact resistance. The highest impact energy, recorded for DRP/2HA3TiO2 of 1.11 J, suggests that an optimal ratio of 2 wt% HA and 3 wt% TiO2 provides the most balanced enhancement of the composite toughness. This balance may arise from the synergistic effect of TiO2, which enhances the toughness through improved particle–matrix interactions, and HA, which contributes to bioactivity and structural reinforcement [30,38]. This also results in a linearity of impact strength, as shown in Table 2. DRP/2HA3TiO2 has the highest impact strength with 297.33 J/m2 followed by DRP/4HA1TiO2, DRP/1HA4TiO2, and DRP/3HA2TiO2 with values of 288.34, 239.2, and 220.46 J/m2, respectively.

Impact energy of 3D-printing specimens using DRP with the HA–TiO2 additive.
Impact strength of 3D-printing specimens containing DRP with the HA–TiO2 additive
| Composition of the additive TiO2 and HA nanoparticles | Impact strength (J/m2) |
|---|---|
| 1 wt% HA + 4 wt% TiO2 | 239.2 |
| 2 wt% HA + 3 wt% TiO2 | 297.32 |
| 3 wt% HA + 2 wt% TiO2 | 220.46 |
| 4 wt% HA + 1 wt% TiO2 | 288.34 |
Physically, the observed impact energy can be explained by considering how these nanoparticles interact at the microstructural level. TiO2 being a hard material, likely serves to impede crack propagation through the composite, thus increasing its energy absorption capacity. The strong bond between the resin matrix and TiO2 nanoparticles could provide enhanced load transfer during impact, leading to higher energy dissipation before failure. Furthermore, TiO2 may help bridge microcracks, reducing the tendency for brittle fracture [27]. This effect would be diminished at lower TiO2 contents or when the HA content is too high, as observed in DRP/3HA2TiO2 with an impact energy of 0.83 J, where the excess HA might have introduced more brittle fracture behaviour, reducing the energy absorbed before failure [30,39]. HA, while promoting bioactivity and compatibility with dental tissues, tends to be brittle. When its concentration is increased (e.g., in DRP/3HA2TiO2), it can introduce micro-voids or weak spots in the composite, reducing the overall toughness and energy absorption under impact. This brittleness is a well-documented issue with HA-based composites, requiring careful optimisation of its concentration when blended with other reinforcing agents [30].
Additionally, the SLA 3D-printing process itself could influence the composite’s performance. SLA offers high precision, which helps in ensuring uniform distribution of nanoparticles in the matrix. However, any inconsistencies in the curing process could affect the mechanical integrity, potentially explaining slight variations in impact energy between different samples [27]. The use of UV-curable resins in SLA, combined with nanoparticle reinforcements, enables fine-tuning of the material’s mechanical properties, which is crucial for applications requiring both strength and biocompatibility, such as dental implants and bone scaffolds [30].
The impact energy data align well with the trends observed in the hardness test. DRP/1HA4TiO2, which exhibited the highest hardness, also showed a relatively high impact energy of 0.90 J. This suggests that a high TiO2 content not only improves surface hardness but also enhances toughness by improving the materials’ ability to absorb and dissipate energy during impact. Ramanjaneyulu et al. showed that harder composites tend to have higher toughness when well-reinforced composite with nanoparticles TiO2, which act as toughening agents during impact, preventing sudden failure [40].
However, when the HA content increases (e.g., in DRP/3HA2TiO2), the impact energy drops significantly (0.83 J), mirroring the decrease in hardness. This is due to the brittle nature of HA, which promotes crack initiation and propagation, leading to lower energy absorption and reduced impact resistance. The slight recovery in both hardness and impact energy for DRP/4HA1TiO2 highlights the importance of maintaining an optimal balance between reinforcing nanoparticles to achieve both hardness and toughness.
The hardness and impact energy results for the DRP composites reveal that the mechanical properties of these materials are highly dependent on the balance between HA and TiO2 nanoparticles. TiO2 significantly enhances both hardness and impact resistance, while excessive HA introduces brittleness and reduces these properties. By optimising the ratio of these nanoparticles, it is possible to tailor the mechanical performance of the composite for specific applications, particularly in dental and orthopaedic fields where both hardness and toughness are critical.
3.5 SEM
The surface morphology of various composition titanium dioxide and HA is shown in Figure 7. Nanoparticles of HA and titanium dioxide are ceramic materials with a white colour. Figure 7(a) shows that the composition with 4 wt% TiO2 and 1% wt HA had the highest hardness with the lowest wear rate. From the surface morphology, it can be observed that there is a bonding between two different additive particles that have a role in delaying microcracks under load. The bonding of nanoparticles improved the tensile strength [41], and it can be confirmed from Figure 3. Figure 7(b) and (c) shows the presence of micro-voids due to the addition of HA for compositions with 2% wt and 3 wt% HA. Its appearance is certainly the result of the interfacial bonding of TiO2 particles, resulting in voids at certain positions that will affect the mechanical properties of the material [42]. The presence of agglomeration on the surface of specimens indicates the homogeneous dispersion of nanoparticles during the mixing process [41].

SEM morphology of materials: (a) DRP/1HA4TiO2, (b) DRP/2HA3TiO2, (c) DRP/3HA2TiO2, and (d) DRP/4HATiO2 in 3,000× magnification.
In Figure 7(d), it can be seen that with the addition of 4 wt% HA, there is porosity in the specimen surface. The stepped appearance observed during printing highlights the limitations of the layer-by-layer process [43], which can lead to specimen misalignment, increased porosity, and reduced tensile strength. Microscopy images revealed variations in particle dispersion, porosity, and interfacial bonding, all of which contribute to the fluctuations in the mechanical properties of the material. In contrast to the primary explanation that attributes the changes in hardness and impact energy to the interplay between HA and TiO2, another possible perspective could focus on the composite microstructure and processing conditions. The fluctuations in hardness and impact energy, particularly the decrease in hardness for DRP/3HA2TiO2 followed by a recovery in DRP/4HA1TiO2, could also be influenced by factors such as particle agglomeration, void formation, or non-uniform dispersion during the 3D-printing process.
Regarding particle agglomeration and dispersion, while the primary analysis suggests that increasing the HA content introduces brittleness, another potential reason for the decrease in hardness and impact energy in the DRP/3HA2TiO2 sample could be particle agglomeration. When nanoparticles like HA are added in higher composition, they tend to form clusters or agglomerates if not well-dispersed in the polymer matrix. These agglomerates create weak spots, leading to reduced mechanical properties. For example, Zare et al. found that agglomerated nanoparticles could also reduce the mechanical properties of the resulting product [44]. The slight increase in hardness for DRP/4HA1TiO2 may indicate improved dispersion or better particle–polymer interaction at lower TiO2 content, which balances the negative effects of agglomeration and micro-voids. Another factor could be the formation of voids during the SLA printing process. SLA printing can sometimes introduce porosity, which adversely affects mechanical properties.
The DRP/3HA2TiO2 sample, with a higher HA content, could have experienced more significant porosity, so the stress was concentrated around the area. Alshihabi and Kayacan found that concentrated stress could lead to crack formation and enhance the possibility of failure [31]. The slight recovery in the DRP/4HA1TiO2 sample may indicate that the reduced HA content led to less porosity or better curing during the SLA printing process, allowing for more uniform material properties. Interfacial bonding is another mechanism that could be related to the matrix–particle bonding. When there is good adhesion between the resin matrix and the reinforcing nanoparticles, mechanical properties such as hardness and impact resistance improve due to better load transfer between the polymer and the particles. The drop in hardness and impact energy in the DRP/3HA2TiO2 sample might suggest poor bonding at higher HA concentrations, whereas the improvement seen in the DRP/4HA1TiO2 sample could indicate stronger bonding between the matrix and TiO2 at a lower concentration of HA, as suggested by Zare et al. [44].
3.6 Antibacterial assay
Investigation of the antibacterial activity of DRP with the additive titanium dioxide and HA nanoparticles was done with the disc diffusion method. The antibacterial assay used E. coli as the Gram-negative bacterium and S. aureus as the Gram-positive bacterium [45]. Chloramphenicol in disc form with 6 mm diameter was used as a positive control and a blank disc with the same diameter was used as a negative control . Specimen in suspension form was placed in a Petri dish along with control and incubated for 24 h. The results of inhibition zones after incubation are shown in Figure 8. Chloramphenicol is an antibacterial with activity spectrum against Gram-positive as well as Gram-negative bacteria by inhibiting protein synthesis through binding to ribosomes [46]. The inhibition zone that formed around chloramphenicol disc after 24 h of incubation at 37°C with E. coli bacteria was 32.96 mm, and it was 27.49 mm for S. aureus.
Zone of inhibition of 3D-printing specimens against E. coli and S. aureus bacteria: Control positive (+); control negative (−); DRP with the additive HA–TiO2 at various concentrations.
Inhibition zone that formed around the samples of DRP with the additive TiO2–HA nanoparticles was measured and is shown in Figure 9. The highest inhibition zone was observed in the sample DRP/2HA3TiO2 with composition 2 wt% HA and 3 wt% TiO2 for E. coli and S. aureus bacteria were 11.27 and 10.95 mm, respectively. For E. coli bacterium, the inhibition zone that arises in area around the disc showed a fluctuating result. Meanwhile, the inhibition zone for S. aureus bacterium is higher than that of E. coli almost for all of the variation compositions of TiO2-HA nanoparticles. This could happen because Gram-positive bacteria are faster to spread compared with Gram-negative bacteria, so the antibacterial activity would be more prominent in the Petri dish which used S. aureus bacterium due to plasmolysis. Plasmolysis is a condition of separation of the cytoplasm from the cell wall. The cell wall of E. coli bacterium consists of solid lipopolysaccharide, which functions as a barrier to any chemical compound that will damage the bacterial cell wall and kill the bacterium [47].

Inhibition zone of 3D-printing specimens using DRP with the additive HA–TiO2 against E. coli and S. aureus.
In general, HA is a material that shows good bioactivity due to similarity in the structure and chemical compound to human bones [48]. In addition, titanium dioxide is also an inorganic material with good biocompatibility and non-toxicity [49]. In composites with the combination additive of TiO2 and HA nanoparticles, bacteria are attracted to the layer of HA and are killed by titanium dioxide nanoparticles. Thus, the appropriate composition between two additive materials should be considered for obtaining optimum antibacterial activity against both kinds of bacteria. 2 wt% HA and 3 wt% TiO2 was the optimum composition that had the largest inhibition zone compared to other compositions after incubation for 24 h.
4 Conclusions
This research focused on developing a new resin with nanoparticles to improve clinical results. 3D-printing specimens using the DRP as a matrix and the additive titanium dioxide and HA nanoparticles were successfully produced by SLA. The aim of adding nanoparticles to the matrix was to achieve outstanding mechanical properties while still possessing antibacterial properties for dental applications. TiO2 and HA were added in several compositions to obtain the optimum mechanical and biological properties. In response to the need of mechanical properties:
The specimen with 4 wt% TiO2 demonstrated the highest hardness, offering enhanced mechanical properties for dental applications.
Hardness of the material was found to be proportional to the ultimate tensile strength for DRP/1HA4TiO2, which had the highest value of 96.36 MPa.
This composition also displayed the lowest wear rate with 5.96 × 10−8 mm3/Nm, inversely to material hardness and indicating good balance.
The impact energy varied across different compositions, influenced by several factors such as particle agglomeration, poor bonding, non-uniform dispersion, and possibility of porosity, which can be confirmed by the surface morphology condition.
With regard to antibacterial activity, an inhibition zone appeared around the disc of extracted specimen after 24 h of incubation with E. coli and S. aureus bacteria. The sample with composition 2 wt% HA and 3 wt% TiO2 had the largest inhibition zone. Almost for all the samples, the inhibition zone for S. aureus is higher than that for E. coli bacterium due to plasmolysis in the bacterial cell wall.
A balanced composition of HA and titanium dioxide nanoparticles is therefore essential for optimising both mechanical properties and antibacterial activity in 3D-printed dental resin. Further in vivo studies are necessary to obtain the optimum composition of TiO2–HA for dental applications.
Acknowledgments
The authors thank the Ministry of High Education Science and Technology, Republik of Indonesia, for the financial support during the experimental works through the Hibah Grup Riset LPPM UNS. The authors also thank the Ministry of Health, Republic of Indonesia.
-
Funding information: The authors state no funding was involved.
-
Author contributions: Rohmadi: concept, methodology, material testing. Ubaidillah: methodology, mechanical analysis, writing – review and editing. Kuncoro Diharjo: material testing, data collection. Joko Triyono: literature review, biological analysis. Widyanita Harwijayanti: data visualisation, writing – draft preparation. Sunarto Kaleg: morphological testing. Saiful Amri Mazlan: mechanical analysis. All authors have accepted responsibility for the entire content of this manuscript and approved its submission.
-
Conflict of interest: The authors state there is no conflict of interest.
-
Data availability statement: All data generated or analysed during this study are included in this published article.
References
[1] Stevanović M, Đošić M, Janković A, Kojić V, Vukašinović-Sekulić M, Stojanović J, et al. Gentamicin-loaded bioactive hydroxyapatite/chitosan composite coating electrodeposited on titanium. ACS Biomater Sci Eng. 2018;4(12):3994–4007, https://pubs.acs.org/doi/10.1021/acsbiomaterials.8b00859.10.1021/acsbiomaterials.8b00859Search in Google Scholar PubMed
[2] Qin J, Yang D, Maher S, Lima-Marques L, Zhou Y, Chen Y, et al. Micro- and nano-structured 3D printed titanium implants with a hydroxyapatite coating for improved osseointegration. J Mater Chem B. 2018;6(19):3136–44, https://xlink.rsc.org/?DOI=C7TB03251J.10.1039/C7TB03251JSearch in Google Scholar PubMed
[3] Weng Z, Zhou Y, Lin W, Senthil T, Wu L. Structure-property relationship of nano enhanced stereolithography resin for desktop SLA 3D printer. Compos Part A Appl Sci Manuf. 2016;88:234–42. 10.1016/j.compositesa.2016.05.035.Search in Google Scholar
[4] Wu S, Altenried S, Zogg A, Zuber F, Maniura-Weber K, Ren Q. Role of the surface nanoscale roughness of stainless steel on bacterial adhesion and microcolony formation. ACS Omega. 2018;3(6):6456–64, https://pubs.acs.org/doi/10.1021/acsomega.8b00769.10.1021/acsomega.8b00769Search in Google Scholar PubMed PubMed Central
[5] Fang Z, Chen J, Zhu Y, Hu G, Xin H, Guo K, et al. High-throughput screening and rational design of biofunctionalized surfaces with optimized biocompatibility and antimicrobial activity. Nat Commun. 2021;12(1):3757. 10.1038/s41467-021-23954-8.Search in Google Scholar PubMed PubMed Central
[6] Rohmadi R, Harwijayanti W, Ubaidillah U, Triyono J, Diharjo K, Utomo P. In vitro degradation and cytotoxicity of eggshell-based hydroxyapatite: a systematic review and meta-analysis. Polymers (Basel). 2021;13(19):3223, https://www.mdpi.com/2073-4360/13/19/3223.10.3390/polym13193223Search in Google Scholar PubMed PubMed Central
[7] Alshamrani A, Alhotan A, Kelly E, Ellakwa A. Mechanical and biocompatibility properties of 3D-printed dental resin reinforced with glass silica and zirconia nanoparticles: In vitro study. Polymers (Basel). 2023;15(11):2523, https://www.mdpi.com/2073-4360/15/11/2523.10.3390/polym15112523Search in Google Scholar PubMed PubMed Central
[8] Liu M, Jia Z, Jia D, Zhou C. Recent advance in research on halloysite nanotubes-polymer nanocomposite. Prog Polym Sci. 2014;39(8):1498–525. 10.1016/j.progpolymsci.2014.04.004.Search in Google Scholar
[9] Vu AA, Bose S. Natural antibiotic oregano in hydroxyapatite-coated titanium reduces osteoclastic bone resorption for orthopedic and dental applications. ACS Appl Mater Interfaces. 2020;12(47):52383–92, https://pubs.acs.org/doi/10.1021/acsami.0c14993.10.1021/acsami.0c14993Search in Google Scholar PubMed PubMed Central
[10] Spengler C, Nolle F, Mischo J, Faidt T, Grandthyll S, Thewes N, et al. Strength of bacterial adhesion on nanostructured surfaces quantified by substrate morphometry. Nanoscale. 2019;11(42):19713–22, https://xlink.rsc.org/?DOI=C9NR04375F.10.1039/C9NR04375FSearch in Google Scholar
[11] Berger TJ, Spadaro JA, Chapin SE, Becker RO. Electrically generated silver ions: quantitative effects on bacterial and mammalian cells. Antimicrob Agents Chemother. 1976;9(2):357–8. https://journals.asm.org/doi/10.1128/AAC.9.2.357.10.1128/AAC.9.2.357Search in Google Scholar PubMed
[12] Kawashita M, Toda S, Kim HM, Kokubo T, Masuda N. Preparation of antibacterial silver-doped silica glass microspheres by sol-gel method. Key Eng Mater. 2003;240–242:229–32, https://www.scientific.net/KEM.240-242.229.10.4028/www.scientific.net/KEM.240-242.229Search in Google Scholar
[13] Pranjali P, Meher MK, Raj R, Prasad N, Poluri KM, Kumar D, et al. Physicochemical and antibacterial properties of PEGylated zinc oxide nanoparticles dispersed in peritoneal dialysis fluid. ACS Omega. 2019;4(21):19255–64, https://pubs.acs.org/doi/10.1021/acsomega.9b02615.10.1021/acsomega.9b02615Search in Google Scholar PubMed PubMed Central
[14] Liska R, Schuster M, Inführ R, Turecek C, Fritscher C, Seidl B, et al. Photopolymers for rapid prototyping. J Coatings Technol Res. 2007;4(4):505–10. http://link.springer.com/10.1007/s11998-007-9059-3.10.1007/s11998-007-9059-3Search in Google Scholar
[15] Abdullayev E, Sakakibara K, Okamoto K, Wei W, Ariga K, Lvov Y. Natural tubule clay template synthesis of silver nanorods for antibacterial composite coating. ACS Appl Mater Interfaces. 2011;3(10):4040–6, https://pubs.acs.org/doi/10.1021/am200896d.10.1021/am200896dSearch in Google Scholar PubMed
[16] Veerabadran NG, Price RR, Lvov YM. Clay nanotubes for encapsulation and sustained release of drugs. Nano. 2007;2(2):115–20, https://www.worldscientific.com/doi/abs/10.1142/S1793292007000441.10.1142/S1793292007000441Search in Google Scholar
[17] Li Y, Zhang Y, Zhang Y, Liu M, Zhang F, Wang L. Thermal behavior analysis of halloysite selected from Inner Mongolia Autonomous Region in China. J Therm Anal Calorim. 2017;129(3):1333–9. http://link.springer.com/10.1007/s10973-017-6324-2.10.1007/s10973-017-6324-2Search in Google Scholar
[18] Chen Q, Zhao Y, Wu W, Xu T, Fong H. Fabrication and evaluation of Bis-GMA/TEGDMA dental resins/composites containing halloysite nanotubes. Dent Mater. 2012;28(10):1071–9. 10.1016/j.dental.2012.06.007.Search in Google Scholar PubMed PubMed Central
[19] International ASTM. Standard test method for rockwell hardness of plastics and electrical insulating materials. In ASTM D785-03. United States of America: ASTM International; 2011. p. 1–6.Search in Google Scholar
[20] International ASTM. Standard test method for tensile properties of plastics. In ASTM D638-14. United States of America: ASTM International; 2000. p. 3–4.Search in Google Scholar
[21] Alomarah A, Ruan D, Masood S, Sbarski I, Faisal B. An investigation of in-plane tensile properties of re-entrant chiral auxetic structure. Int J Adv Manuf Technol. 2018;96(5–8):2013–29.10.1007/s00170-018-1605-xSearch in Google Scholar
[22] International ASTM. Standard test method for unnotched cantilever beam impact resistance of plastics. In ASTM D4812-99. United States of America: ASTM International; 2017. p. 4–6.Search in Google Scholar
[23] International ASTM. Standard test method for wear and friction testing with a pin-on-disk or ball-on-disk apparatus. In ASTM G99-23. United States of America: ASTM International; 2018. p. 3–5.Search in Google Scholar
[24] ISO. Biological evaluation of medical devices. In ISO 10993-5:2009. International Organization for Standardization; 2017. p. 1897–904.Search in Google Scholar
[25] Li X, Yao C, Shen J, Zhu S, Kong Y, Yao C, et al. The impact of titanium hydroxyapatite doping on the mechanical and biological properties of photocured resin. Micromachines. 2024;15(8):1040, https://www.mdpi.com/2072-666X/15/8/1040.10.3390/mi15081040Search in Google Scholar PubMed PubMed Central
[26] Boronat T, Fombuena V, Garcia-Sanoguera D, Sanchez-Nacher L, Balart R. Development of a biocomposite based on green polyethylene biopolymer and eggshell. Mater Des. 2015;68:177–85. 10.1016/j.matdes.2014.12.027.Search in Google Scholar
[27] Rooney K, Dong Y, Basak AK, Pramanik A. Prediction of mechanical properties of 3D printed particle-reinforced resin composites. J Compos Sci. 2024;8(10):416, https://www.mdpi.com/2504-477X/8/10/416.10.3390/jcs8100416Search in Google Scholar
[28] Ramesh N, Moratti SC, Dias GJ. Hydroxyapatite–polymer biocomposites for bone regeneration: A review of current trends. J Biomed Mater Res Part B Appl Biomater. 2018;106(5):2046–57. https://onlinelibrary.wiley.com/doi/10.1002/jbm.b.33950.10.1002/jbm.b.33950Search in Google Scholar PubMed
[29] Yahyaa MM, Aleabi S. Enhancing some mechanical properties (Compression, Impact, Hardness, Young modulus) and thermal conductivity, diffusion coefficient of micro epoxy composites. Ibn AL-Haitham J Pure Appl Sci. 2022;35(3):32–43, https://jih.uobaghdad.edu.iq/index.php/j/article/view/2841.10.30526/35.3.2841Search in Google Scholar
[30] Han Y, Wei Q, Chang P, Hu K, Okoro OV, Shavandi A, et al. Three-dimensional printing of hydroxyapatite composites for biomedical application. Crystals. 2021;11(4):353, https://www.mdpi.com/2073-4352/11/4/353.10.3390/cryst11040353Search in Google Scholar
[31] Alshihabi M, Kayacan MY. Effect of nanosized carbon nanotubes, Titanium Nitride and cubic Boron Nitride powders on mechanical and thermal properties of SLA 3D printed resin composites. Polym Compos. 2024;45(17):15561–73. https://4spepublications.onlinelibrary.wiley.com/doi/10.1002/pc.28850.10.1002/pc.28850Search in Google Scholar
[32] e-SUN. Dental model resin; 2021. p. 1–2.Search in Google Scholar
[33] Tu S, Ren X, He J, Zhang Z. Stress–strain curves of metallic materials and post‐necking strain hardening characterization: A review. Fatigue Fract Eng Mater Struct. 2020;43(1):3–19. https://onlinelibrary.wiley.com/doi/10.1111/ffe.13134.10.1111/ffe.13134Search in Google Scholar
[34] Diederichs EV, Mondal D, Willett TL. The effects of physiologically relevant environmental conditions on the mechanical properties of 3D-printed biopolymer nanocomposites. J Mech Behav Biomed Mater. 2024;159:106694. 10.1016/j.jmbbm.2024.106694.Search in Google Scholar PubMed
[35] Pratiwi U, Cahyanto WT. The elastic properties of objects by determining Young’s modulus for the characterization of metal raw materials using a speed sensor encoder and a load cell sensor. SAGA J Technol Inf Syst. 2023;1(2):22–30.10.58905/saga.v1i2.60Search in Google Scholar
[36] Lemm JD, Warmuth AR, Pearson SR, Shipway PH. The influence of surface hardness on the fretting wear of steel pairs – Its role in debris retention in the contact. Tribol Int. 2015;81:258–66, https://linkinghub.elsevier.com/retrieve/pii/S0301679X14003272.10.1016/j.triboint.2014.09.003Search in Google Scholar
[37] Gopi V, Sellamuthu R, Arul S. Measurement of hardness, wear rate and coefficient of friction of surface refined Al-Cu alloy. Procedia Eng. 2014;97:1355–60. 10.1016/j.proeng.2014.12.416.Search in Google Scholar
[38] Thurzo A, Gálfiová P, Nováková ZV, Polák Š, Varga I, Strunga M, et al. Fabrication and in vitro characterization of novel hydroxyapatite scaffolds 3D printed using polyvinyl alcohol as a thermoplastic binder. Int J Mol Sci. 2022;23(23):14870, https://www.mdpi.com/1422-0067/23/23/14870.10.3390/ijms232314870Search in Google Scholar PubMed PubMed Central
[39] Wang Y, Li X, Li C, Yang M, Wei Q. Binder droplet impact mechanism on a hydroxyapatite microsphere surface in 3D printing of bone scaffolds. J Mater Sci. 2015;50(14):5014–23. http://link.springer.com/10.1007/s10853-015-9050-9.10.1007/s10853-015-9050-9Search in Google Scholar
[40] Ramanjaneyulu S, Murthy BSN, Kumar SP, Gupta PS. Enhancing HDPE properties: Impact of nano-TiO2 and nano-SiO2 particles on mechanical properties and wear resistance. J Inst Eng Ser D. 2024;1–15. 10.1007/s40033-024-00758-w.Search in Google Scholar
[41] Mondal D, Willett TL. Enhanced mechanical performance of mSLA-printed biopolymer nanocomposites due to phase functionalization. J Mech Behav Biomed Mater. 2022;135:105450. 10.1016/j.jmbbm.2022.105450.Search in Google Scholar PubMed
[42] Hyde A, He J, Cui X, Lua J, Liu L. Effects of microvoids on strength of unidirectional fiber-reinforced composite materials. Compos Part B Eng. 2020;187:107844. 10.1016/j.compositesb.2020.107844.Search in Google Scholar
[43] Kalilayeva A, Zhumashev D, Wei D, Perveen A, Talamona D. Investigation of stereolithography additively manufactured components for deviations in dimensional and geometrical features. Polymers (Basel). 2024;16(23):3311, https://www.mdpi.com/2073-4360/16/23/3311.10.3390/polym16233311Search in Google Scholar PubMed PubMed Central
[44] Zare Y, Rhee KY, Hui D. Influences of nanoparticles aggregation/agglomeration on the interfacial/interphase and tensile properties of nanocomposites. Compos Part B Eng. 2017;122:41–6, https://linkinghub.elsevier.com/retrieve/pii/S1359836817307461.10.1016/j.compositesb.2017.04.008Search in Google Scholar
[45] Harwijayanti W, Ubaidillah U, Triyono J. Physicochemical characterization and antibacterial activity of titanium/shellac-coated hydroxyapatite composites. Coatings. 2022;12(5):680, https://www.mdpi.com/2079-6412/12/5/680.10.3390/coatings12050680Search in Google Scholar
[46] Fitzgerald KT, Vera R. Reported toxicities in reptiles. In Reptile medicine and surgery. 2nd edn. Missouri: Elsevier; 2006. p. 1068–80. 10.1016/B0-7216-9327-X/50087-0.Search in Google Scholar
[47] Noviyanti AR, Asyiah EN, Permana MD, Dwiyanti D, Suryana, Eddy DR. Preparation of hydroxyapatite-titanium dioxide composite from eggshell by hydrothermal method: characterization and antibacterial activity. Crystals. 2022;12(11):1599, https://www.mdpi.com/2073-4352/12/11/1599.10.3390/cryst12111599Search in Google Scholar
[48] Pandey A, Midha S, Sharma RK, Maurya R, Nigam VK, Ghosh S, et al. Antioxidant and antibacterial hydroxyapatite-based biocomposite for orthopedic applications. Mater Sci Eng C. 2018;88:13–24. 10.1016/j.msec.2018.02.014.Search in Google Scholar PubMed
[49] Elsaka SE, Hamouda IM, Swain MV. Titanium dioxide nanoparticles addition to a conventional glass-ionomer restorative: Influence on physical and antibacterial properties. J Dent. 2011;39(9):589–98. https://linkinghub.elsevier.com/retrieve/pii/S030057121100128X.10.1016/j.jdent.2011.05.006Search in Google Scholar PubMed
© 2025 the author(s), published by De Gruyter
This work is licensed under the Creative Commons Attribution 4.0 International License.
Articles in the same Issue
- Research Articles
- Probing microstructural evolution and surface hardening of AISI D3 steel after multistage heat treatment: An experimental and numerical analysis
- Activation energy of lime cement containing pozzolanic materials
- Optimizing surface quality in PMEDM using SiC powder material by combined solution response surface methodology – Adaptive neuro fuzzy inference system
- Experimental study of the mechanical shear behaviour of steel rebar connectors in timber–concrete structure with leafy wood species
- Development of structural grade lightweight geopolymer concrete using eco-friendly materials
- An experimental approach for the determination of the physical and mechanical properties of a sustainable geopolymer mortar made with Algerian ground-granulated blast furnace slag
- Effect of using different backing plate materials in autogenous TIG welding on bead geometry, microhardness, tensile strength, and fracture of 1020 low carbon steel
- Uncertainty analysis of bending response of flexoelectric nanocomposite plate
- Leveraging normal distribution and fuzzy S-function approaches for solar cell electrical characteristic optimization
- Effect of medium-density fiberboard sawdust content on the dynamic and mechanical properties of epoxy-based composite
- Mechanical properties of high-strength cement mortar including silica fume and reinforced with single and hybrid fibers
- Study the effective factors on the industrial hardfacing for low carbon steel based on Taguchi method
- Analysis of the combined effects of preheating and welding wire feed rates on the FCAW bead geometric characteristics of 1020 steel using fuzzy logic-based prediction models
- Effect of partially replacing crushed oyster shell as fine aggregate on the shear behavior of short RC beams using GFRP rebar strengthened with TRC: Experimental and numerical studies
- Micromechanic models for manufacturing quality prediction of cantula fiber-reinforced nHA/magnesium/shellac as biomaterial composites
- Numerical simulations of the influence of thermal cycling parameters on the mechanical response of SAC305 interconnects
- Impact of nanoparticles on the performance of metakaolin-based geopolymer composites
- Enhancing mechanical and thermal properties of epoxy-based polymer matrix composites through hybrid reinforcement with carbon, glass and steel
- Prevention of crack kinetic development in a damaged rod exposed to an aggressive environment
- Ideal strain gauge location for evaluating stress intensity factor in edge-cracked aluminum plates
- Experimental and multiscale numerical analysis of elastic mechanical properties and failure in woven fabric E-glass/polyester composites
- Optimizing piezoelectric patch placement for active repair of center-cracked plates
- Experimental investigation on the transverse crushing performance of 3D printed polymer composite filled aluminium tubes
- Review Articles
- Advancing asphaltic rail tracks: Bridging knowledge gaps and challenges for sustainable railway infrastructure
- Chemical stabilization techniques for clay soil: A comprehensive review
- Development and current milestone of train braking system based on failure phenomenon and accident case
- Rapid Communication
- The role of turbulence in bottom-up nanoparticle synthesis using ultrafast laser filamentation in ethanol
- Special Issue on Deformation and Fracture of Advanced High Temperature Materials - Part II
- Effect of parameters on thermal stress in transpiration cooling of leading-edge with layered gradient
- Development of a piezo actuator-based fatigue testing machine for miniature specimens and validation of size effects on fatigue properties
- Development of a 1,000°C class creep testing machine for ultraminiature specimens and feasibility verification
- Special Issue on Advances in Processing, Characterization and Sustainability of Modern Materials - Part II
- Surface integrity studies in microhole drilling of Titanium Beta-C alloy using microEDM
- Experimental investigation on bacterial concrete by using Cantabro loss and UPV
- Influence of gas nitriding on the surface layer of M50 NiL steel for aerospace-bearing applications
- Experimental investigation on the spectral, mechanical, and thermal behaviors of thermoplastic starch and de-laminated talc-filled sustainable bio-nanocomposite of polypropylene
- Synthesis and characterization of sustainable hybrid bio-nanocomposite of starch and polypropylene for electrical engineering applications
- Microstructural and mechanical characterization of Al6061-ZrB2 nanocomposites fabricated by powder metallurgy
- Effect of edge preparation on hardness and corrosion behaviour of AA6061-T651 friction stir welds
- Mechanical improvement in acetal composites reinforced with graphene nanotubes and Teflon fibers using loss functions
- Experimental investigation on the mechanical properties of aluminum-based metal matrix composites by the squeeze casting method
- Investigation on punch force–displacement and thickness changes in the shallow drawing of AA2014 aluminium alloy sheets using finite element simulations
- Influence of liquid nitriding on the surface layer of M50 NiL steel for bearing applications
- Mechanical and tribological analyses of Al6061-GO/CNT hybrid nanocomposites by combined vacuum-assisted and ultrasonicated stir casting method
- Strengthening of structures with bacterial concrete for effective crack repair and durability enhancement
- Unique approaches in developing novel nano-composites: Evaluating their mechanical and tribological characteristics
- Load-carrying capacity of highly compact rigid deployable booms
- Investigating the influence of SiC and B4C reinforcements on the mechanical and microstructural properties of stir-casted magnesium hybrid composites
- Evaluation of mechanical and performance characteristics of bitumen mixture using waste septage ash as partial substitute
- Mechanical characterization of carbon/Kevlar hybrid woven 3D composites
- Development of a 3D-printed cervical collar using biocompatible and sustainable polylactic acid
- Mechanical characterization of walnut shell powder-reinforced neem shell liquid composite
- Special Issue on Structure-energy Collaboration towards Sustainability Societies
- Effect of tunneling conductivity of CNTs on the EMI shielding effectiveness of nanocomposite in the C-band
- Evaluation of the effect of material selection and core geometry in thin-walled sandwich structures due to compressive strength using a finite element method
- Special Issue on Sustainability and Development in Civil Engineering - Part III
- The optimum reinforcement length for ring footing resting on sandy soils resisting inclined load
- Special Issue on Advanced Materials in Industry 4.0
- Cross-dataset evaluation of deep learning models for crack classification in structural surfaces
- Mechanical and antibacterial characteristics of a 3D-printed nano-titanium dioxide–hydroxyapatite dental resin-based composite
Articles in the same Issue
- Research Articles
- Probing microstructural evolution and surface hardening of AISI D3 steel after multistage heat treatment: An experimental and numerical analysis
- Activation energy of lime cement containing pozzolanic materials
- Optimizing surface quality in PMEDM using SiC powder material by combined solution response surface methodology – Adaptive neuro fuzzy inference system
- Experimental study of the mechanical shear behaviour of steel rebar connectors in timber–concrete structure with leafy wood species
- Development of structural grade lightweight geopolymer concrete using eco-friendly materials
- An experimental approach for the determination of the physical and mechanical properties of a sustainable geopolymer mortar made with Algerian ground-granulated blast furnace slag
- Effect of using different backing plate materials in autogenous TIG welding on bead geometry, microhardness, tensile strength, and fracture of 1020 low carbon steel
- Uncertainty analysis of bending response of flexoelectric nanocomposite plate
- Leveraging normal distribution and fuzzy S-function approaches for solar cell electrical characteristic optimization
- Effect of medium-density fiberboard sawdust content on the dynamic and mechanical properties of epoxy-based composite
- Mechanical properties of high-strength cement mortar including silica fume and reinforced with single and hybrid fibers
- Study the effective factors on the industrial hardfacing for low carbon steel based on Taguchi method
- Analysis of the combined effects of preheating and welding wire feed rates on the FCAW bead geometric characteristics of 1020 steel using fuzzy logic-based prediction models
- Effect of partially replacing crushed oyster shell as fine aggregate on the shear behavior of short RC beams using GFRP rebar strengthened with TRC: Experimental and numerical studies
- Micromechanic models for manufacturing quality prediction of cantula fiber-reinforced nHA/magnesium/shellac as biomaterial composites
- Numerical simulations of the influence of thermal cycling parameters on the mechanical response of SAC305 interconnects
- Impact of nanoparticles on the performance of metakaolin-based geopolymer composites
- Enhancing mechanical and thermal properties of epoxy-based polymer matrix composites through hybrid reinforcement with carbon, glass and steel
- Prevention of crack kinetic development in a damaged rod exposed to an aggressive environment
- Ideal strain gauge location for evaluating stress intensity factor in edge-cracked aluminum plates
- Experimental and multiscale numerical analysis of elastic mechanical properties and failure in woven fabric E-glass/polyester composites
- Optimizing piezoelectric patch placement for active repair of center-cracked plates
- Experimental investigation on the transverse crushing performance of 3D printed polymer composite filled aluminium tubes
- Review Articles
- Advancing asphaltic rail tracks: Bridging knowledge gaps and challenges for sustainable railway infrastructure
- Chemical stabilization techniques for clay soil: A comprehensive review
- Development and current milestone of train braking system based on failure phenomenon and accident case
- Rapid Communication
- The role of turbulence in bottom-up nanoparticle synthesis using ultrafast laser filamentation in ethanol
- Special Issue on Deformation and Fracture of Advanced High Temperature Materials - Part II
- Effect of parameters on thermal stress in transpiration cooling of leading-edge with layered gradient
- Development of a piezo actuator-based fatigue testing machine for miniature specimens and validation of size effects on fatigue properties
- Development of a 1,000°C class creep testing machine for ultraminiature specimens and feasibility verification
- Special Issue on Advances in Processing, Characterization and Sustainability of Modern Materials - Part II
- Surface integrity studies in microhole drilling of Titanium Beta-C alloy using microEDM
- Experimental investigation on bacterial concrete by using Cantabro loss and UPV
- Influence of gas nitriding on the surface layer of M50 NiL steel for aerospace-bearing applications
- Experimental investigation on the spectral, mechanical, and thermal behaviors of thermoplastic starch and de-laminated talc-filled sustainable bio-nanocomposite of polypropylene
- Synthesis and characterization of sustainable hybrid bio-nanocomposite of starch and polypropylene for electrical engineering applications
- Microstructural and mechanical characterization of Al6061-ZrB2 nanocomposites fabricated by powder metallurgy
- Effect of edge preparation on hardness and corrosion behaviour of AA6061-T651 friction stir welds
- Mechanical improvement in acetal composites reinforced with graphene nanotubes and Teflon fibers using loss functions
- Experimental investigation on the mechanical properties of aluminum-based metal matrix composites by the squeeze casting method
- Investigation on punch force–displacement and thickness changes in the shallow drawing of AA2014 aluminium alloy sheets using finite element simulations
- Influence of liquid nitriding on the surface layer of M50 NiL steel for bearing applications
- Mechanical and tribological analyses of Al6061-GO/CNT hybrid nanocomposites by combined vacuum-assisted and ultrasonicated stir casting method
- Strengthening of structures with bacterial concrete for effective crack repair and durability enhancement
- Unique approaches in developing novel nano-composites: Evaluating their mechanical and tribological characteristics
- Load-carrying capacity of highly compact rigid deployable booms
- Investigating the influence of SiC and B4C reinforcements on the mechanical and microstructural properties of stir-casted magnesium hybrid composites
- Evaluation of mechanical and performance characteristics of bitumen mixture using waste septage ash as partial substitute
- Mechanical characterization of carbon/Kevlar hybrid woven 3D composites
- Development of a 3D-printed cervical collar using biocompatible and sustainable polylactic acid
- Mechanical characterization of walnut shell powder-reinforced neem shell liquid composite
- Special Issue on Structure-energy Collaboration towards Sustainability Societies
- Effect of tunneling conductivity of CNTs on the EMI shielding effectiveness of nanocomposite in the C-band
- Evaluation of the effect of material selection and core geometry in thin-walled sandwich structures due to compressive strength using a finite element method
- Special Issue on Sustainability and Development in Civil Engineering - Part III
- The optimum reinforcement length for ring footing resting on sandy soils resisting inclined load
- Special Issue on Advanced Materials in Industry 4.0
- Cross-dataset evaluation of deep learning models for crack classification in structural surfaces
- Mechanical and antibacterial characteristics of a 3D-printed nano-titanium dioxide–hydroxyapatite dental resin-based composite